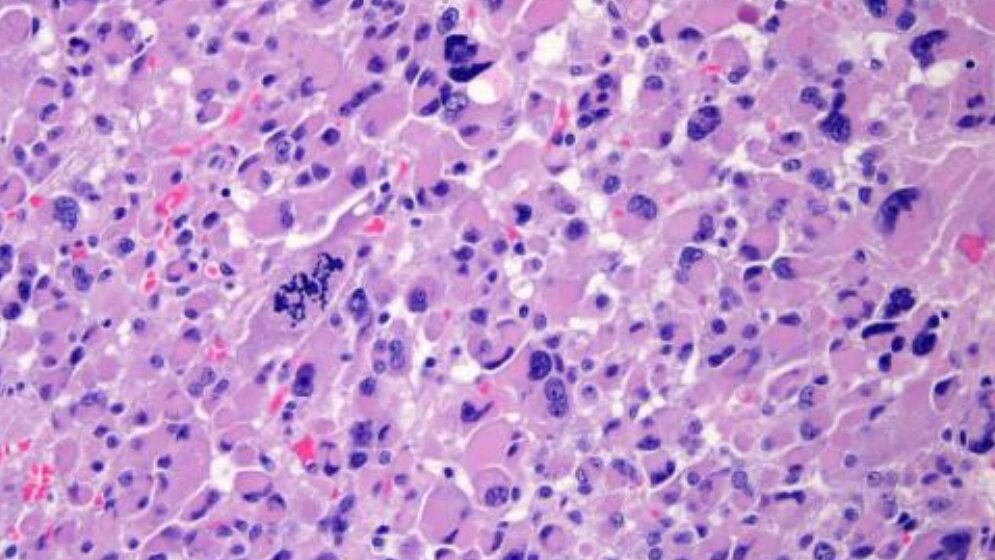
Nebennierenkarzinom_Schnitt_blaue_Bereiche_Zellkerne_Zytoplasma_lila_eingefaerbt_Uniklinikum_Wuerzburg_19052016.jpg Nebennierenkarzinom-Schnitt

Forschergruppen aus 39 Institutionen in Europa, Nordamerika, Südamerika und Australien haben Proben von 91 Nebennierenkarzinomen gesammelt und untersucht. Sie führten eine umfassende genomische Analyse als Teil des renommierten „Cancer Genome Atlas Research Network“ durch. Ihre Ergebnisse veröffentlichten die Wissenschaftler kürzlich.
Zahl der bekannten genetischen Treiber verdoppelt
Die Studie nennt mehrere neue Gene, die zur Entstehung von Nebennierenkrebs führen. Tatsächlich konnte hier die Anzahl der bekannten genetischen Treiber durch die Studie verdoppelt werden. "Diese Daten haben Auswirkungen auf die Diagnose und die Prognose des Nebennierenrindenkarzinoms. Sie erlauben uns, tief in die Biologie der Krankheit zu blicken und zu verstehen, wie diese neuen Gen-Mutationen zu der Nebennierentumorentstehung und Progression der Erkrankung beitragen", sagt Professor Martin Fassnacht, Leiter der Endokrinologie am Universitätsklinikum Würzburg und europäischer Koordinator der Studie.
Zusammenarbeit war der Schlüssel zum Erfolg dieses Projektes
Das Nebennierenrindenkarzinom betrifft jährlich durchschnittlich nur zwei Menschen pro eine Million weltweit. Weil die Erkrankung so selten ist, behandelt eine Institution alleine jährlich nicht genug Patienten, um aussagekräftige Forschung zu betreiben. "Wir arbeiten seit dem Jahr 2003 daran, Nebennierenkrebsnetzwerke aufzubauen", sagt Fassnacht.
Im Jahr 2003 wurde auf Initiative des Schwerpunkts für Endokrinologie und Diabetologie des Uniklinikums Würzburg das Deutsche Nebennierenkarzinom-Register etabliert, das 2009 in das erste Europäische Netzwerk für das Studium der adrenalen Tumoren integriert wurde. Daher waren die Würzburger Gruppe und ihre europäischen Partner sofort dabei, als das Cancer Genome Atlas Research Network die Erforschung des Nebennierenrindenkarzinoms als sein erstes Projekt zu seltenen Krebserkrankungen ankündigte.
Ein neues Verständnis
Die Studie ergab viele Erkenntnisse, sagt Dr. Silviu Sbiera, einer der beteiligten naturwissenschaftlichen Hormonforscher aus Würzburg. Eine der spannendsten Mutationen wurde im Gen „ZNRF3“ gefunden. Bis zu 20 Prozent der untersuchten Nebennierenkrebsproben weisen eine Mutation in diesem Gen auf.
###more###
Zudem konnte die Studie zeigen, dass Mutationen, die bei gutartigen Nebennierenrindenerkrankungen beteiligt waren, eine Rolle in der Entstehung von Nebennierenkrebs spielen könnten.
Eine weitere wichtige Erkenntnis ist, dass viele Nebennierentumoren eine Verdopplung des gesamten Genoms aufweisen: "Ein Phänomen, bei dem jedes Chromosom in einem Genom dupliziert wird", sagt Sbiera. Dies spiegele die Instabilität des Krebsgenoms wider, die im Nebennierenkrebs besonders stark ausgeprägt sei.
"Wenn wir die Mechanismen verstehen, wird uns dies möglicherweise helfen, neue Therapiemöglichkeiten zu finden" sagt Martin Fassnacht, der weitere klinische Studien zum Nebennierenkarzinom leitet.
Künftige Fortschritte in der Behandlung
Die Forscher identifizierten drei verschiedene Subtypen des Nebennierenrindenkarzinoms – basierend auf ihren molekularen Veränderungen. Diese Subtypen waren mit unterschiedlichen Überlebenschancen der Patienten assoziiert. Das deutet darauf hin, dass molekulare Biomarker verwendet werden könnten, um die Patienten zu identifizieren, die wahrscheinlich eine aggressivere Form der Erkrankung haben. Diese Patienten könnten somit von einer besser angepassten Therapie profitieren.
"Unsere Ergebnisse stellen die bislang vollständigste Charakterisierung der Nebennierenrindenkarzinome dar und könnten der Schlüssel für eine erfolgreichere Therapie sein", sagt Sbiera.
Ergebnisse "Open Source"
Die vollständigen Daten dieses Projekts wurden in frei zugänglichen Datenbanken veröffentlicht, sodass jeder Forscher weltweit darauf zugreifen kann, um neue Ideen zu entwickeln, die zu einem besseren Verständnis dieser Art von Krebs führen können.
Dieser "Open-Source-Gedanke" ist besonders wichtig für Nebennierenkrebs-Spezialisten. Die Überlebensraten von Patienten mit Nebennierenrindenkarzinom sind sehr gering, da die Erkrankung oft zu spät diagnostiziert wird. Darüber hinaus führte die Seltenheit dieser Erkrankung dazu, dass seit den 1970er Jahren keine neuen Behandlungsmöglichkeiten mehr entwickelt wurden.
„Wir sind sehr motiviert, auf Basis der neu gewonnenen Erkenntnisse weiter zu forschen, da sie ein enormes Potential darstellen. Die Ergebnisse dieser Arbeit werden hoffentlich neuen Entdeckungen in der Erforschung des Nebennierenrindenkarzinoms sowie anderer Krebserkrankungen den Weg bahnen", sagt Fassnacht. (idw, red)
Hintergrundinformation:
Dieses Projekt wurde finanziell von dem European Research Area Network for Research Programmes on Rare Diseases unterstützt, dem Bundesministerium für Bildung und Forschung, der Deutschen Forschungsgemeinschaft und dem Interdisziplinären Zentrum für Klinische Forschung der Universität Würzburg.
Zheng S, Cherniack AD, Dewal N et al.: Comprehensive Pan-Genomic Characterization of Adrenocortical Carcinoma. Cancer Cell. 2016 May 9;29(5):723-36. DOI: 10.1016/j.ccell.2016.04.002.
Artikel teilen